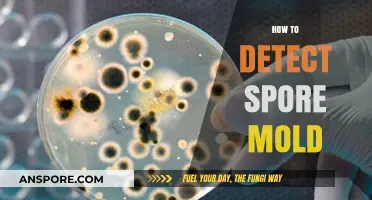
Effective Techniques for Detecting Spore Mold in Your Environment

In the expansive universe of *Spore*, the Grox are a formidable and often feared alien species known for their aggressive behavior and advanced technology, making them a significant challenge for players. For those looking to eliminate the Grox entirely, the process requires strategic planning, resource management, and a deep understanding of the game’s mechanics. Players must first build a powerful empire by advancing through the game’s stages, focusing on developing advanced weaponry, robust spacecraft, and strong alliances with other species. Utilizing rogue planets, terraforming, and strategic attacks on Grox colonies can weaken their hold on the galaxy. Additionally, exploiting their vulnerabilities, such as their reliance on specific resources or their predictable AI, can turn the tide in favor of the player. While destroying the Grox is a daunting task, it is achievable with patience, creativity, and a well-executed plan.
| Characteristics | Values |
|---|---|
| Game Version | Spore Galactic Edition (latest patch) |
| Grox Homeworld | Grox Empyrean (located in the center of the galaxy) |
| Grox Strength | High health, powerful weapons, and advanced technology |
| Grox Weakness | Vulnerable to rogue planets, black holes, and player-built weapons |
| Effective Strategies | 1. Rogue Planet Collision 2. Black Hole Exploitation 3. Advanced Player Weapons 4. Alliance Building 5. Stealth and Hit-and-Run Tactics |
| Required Player Stage | Space Stage (fully upgraded ship and weapons) |
| Time Investment | Several hours to days, depending on strategy and execution |
| Difficulty Level | Very High (requires skill, patience, and resources) |
| Grox Population | Approximately 200-300 planets (varies by game instance) |
| Grox Defense | Strong fleet presence, advanced turrets, and rapid response |
| Player Tools Needed | Maxed-out weapons, rogue planet spawner (if using that strategy), and allies |
| Success Rate | Moderate to High (with proper strategy and execution) |
| Post-Destruction Effects | Unlocks Grox technology, reduces galaxy threat level, and frees colonized planets |
| Community Tips | Save often, scout Grox territories, and exploit environmental hazards |
Explore related products
What You'll Learn
- Exploit Weaknesses: Target Grox cities, use spore-based attacks, and exploit their slow reaction times
- Ally with Empires: Form alliances with neighboring empires to overwhelm Grox collectively
- Tech Superiority: Research advanced weapons and shields to outmatch Grox technology
- Guerilla Tactics: Use hit-and-run strategies to weaken Grox defenses gradually
- Economic Sabotage: Destroy Grox trade routes and resource hubs to cripple their economy

Exploit Weaknesses: Target Grox cities, use spore-based attacks, and exploit their slow reaction times
The Grox, the formidable galactic empire in *Spore*, are not invincible. Their cities, sprawling hubs of activity, are both their strength and their Achilles' heel. By targeting these urban centers, you disrupt their resource flow, communication, and defense coordination. A well-planned assault on a Grox city can cripple their ability to retaliate effectively, turning the tide of battle in your favor.
Spore-based attacks are particularly effective against the Grox due to their biological vulnerabilities. Deploying spore clouds or spore-emitting creatures near their cities can induce widespread chaos. The Grox’s slow reaction times exacerbate this weakness, as they struggle to adapt to rapidly spreading biological threats. For maximum impact, use spore attacks in conjunction with ground assaults, ensuring their defenses are overwhelmed from multiple fronts.
Exploiting the Grox’s sluggish response is key to a successful campaign. Their advanced technology is offset by their inability to react swiftly to unexpected threats. Use hit-and-run tactics, striking their cities and retreating before they can mount a counterattack. Focus on high-value targets like power generators or communication arrays to maximize disruption. Patience is crucial—allow their defenses to weaken over time before launching a decisive blow.
Practical tips include equipping your creatures with spore-emitting abilities and ensuring they have high mobility to evade retaliation. Use stealth to approach Grox cities undetected, and time your attacks when their defenses are at their lowest, such as during resource collection phases. Remember, the goal is not just destruction but strategic debilitation, forcing the Grox into a defensive posture that limits their ability to expand or counterattack. By leveraging their weaknesses, you can systematically dismantle their empire and secure your dominance in the galaxy.
Exploring Spore Print Prices: A Guide to Current Market Values
You may want to see also

Ally with Empires: Form alliances with neighboring empires to overwhelm Grox collectively
In the vast galaxy of Spore, the Grox pose a formidable threat, but their strength can be countered through strategic alliances. By forming coalitions with neighboring empires, players can leverage collective power to overwhelm the Grox. This approach not only distributes the risk but also amplifies the offensive and defensive capabilities of all involved parties. The key lies in identifying allies with compatible goals and sufficient resources, ensuring a unified front against the common enemy.
To initiate alliances, players should focus on diplomatic efforts, offering trade agreements, technology exchanges, or mutual defense pacts. Empires that share borders with Grox territories are ideal candidates, as they are likely already engaged in skirmishes and will benefit from additional support. Use the game’s diplomacy interface to gauge their disposition and propose alliances. Be prepared to offer incentives, such as military aid or resource sharing, to secure their commitment. Once alliances are formed, coordinate attacks to target Grox strongholds simultaneously, minimizing retaliation risks.
A critical aspect of this strategy is maintaining communication and trust among allies. Missteps in coordination can lead to fractured alliances or unintended conflicts. Establish clear objectives and assign roles based on each empire’s strengths—for instance, one ally might focus on ground assaults while another provides orbital support. Regularly monitor alliance health through the game’s relationship tracker and address grievances promptly to prevent defections. Remember, the Grox are relentless, and a united front is essential for sustained success.
While allying with empires is effective, it’s not without challenges. Some empires may demand excessive resources or betray the alliance for their gain. To mitigate this, diversify alliances by partnering with multiple empires, reducing dependency on any single ally. Additionally, maintain a strong independent fleet as a contingency. This strategy not only ensures survival if alliances falter but also reinforces your position as a valuable ally. With careful planning and execution, collective action can turn the tide against the Grox, transforming their dominance into a shared victory.
Stun Spore's Effectiveness: Can It Paralyze Ground-Type Pokémon?
You may want to see also

Tech Superiority: Research advanced weapons and shields to outmatch Grox technology
The Grox, with their advanced technology and aggressive nature, pose a significant threat in *Spore*. To counter their dominance, achieving tech superiority is paramount. This involves a focused effort on researching and developing advanced weapons and shields that surpass Grox capabilities. By outmatching their technology, you can turn the tide of battle and ensure your civilization’s survival.
Step 1: Prioritize Research in the Space Stage
Once you enter the Space Stage, allocate a substantial portion of your resources to the "Tools" section of the research tree. Focus on upgrading your weapons to Plasma and Nano levels, which deal significantly more damage than basic laser or missile weapons. Simultaneously, invest in shield upgrades to increase your defense against Grox attacks. Each upgrade requires specific resources like Neuranium and Red Spice, so establish trade routes or conquer planets rich in these materials to fuel your research.
Step 2: Leverage Alliance and Trade for Faster Progress
While researching, form alliances with neighboring empires to gain access to their technology and resources. Trading with allied empires can provide the rare materials needed for advanced upgrades. However, be cautious—some empires may betray you if they sense weakness. Maintain a strong military presence to deter betrayal while benefiting from their technological contributions.
Step 3: Test and Optimize Your Arsenal
Before confronting the Grox, test your new weapons and shields against weaker opponents. Engage in skirmishes with pirate fleets or rogue empires to gauge the effectiveness of your upgrades. Adjust your ship’s loadout to maximize damage output and defensive capabilities. For example, equip Plasma Launchers for long-range attacks and pair them with Nano Shields to withstand heavy fire.
Caution: Avoid Direct Confrontation Until Fully Prepared
The Grox’s technology is formidable, and premature engagement can lead to devastating losses. Ensure your entire fleet is equipped with advanced weapons and shields before launching a full-scale assault. Additionally, scout Grox territories to identify weaker outposts or fleets, targeting them first to minimize casualties and gain strategic advantages.
By systematically researching and deploying advanced weapons and shields, you can neutralize the Grox’s technological edge. This approach not only ensures your survival but also paves the way for conquering their empire. Patience, resource management, and strategic planning are essential—with tech superiority, the Grox’s reign of terror can be brought to an end.
Mastering Spore: A Step-by-Step Guide to Adding Your Creations
You may want to see also

Guerilla Tactics: Use hit-and-run strategies to weaken Grox defenses gradually
The Grox, with their advanced technology and aggressive nature, can seem like an insurmountable foe in *Spore*. However, their strength lies in their centralized defenses and predictable patterns. Guerilla tactics, characterized by hit-and-run strategies, exploit these weaknesses by avoiding direct confrontation and focusing on gradual attrition. This approach is particularly effective for players who lack the firepower to challenge the Grox head-on.
To implement this strategy, begin by identifying key Grox outposts or fleet concentrations. Use stealth to approach these targets, avoiding detection by staying out of their sensor range. Once in position, launch a swift attack on a single ship or structure, prioritizing high-value targets like command vessels or resource hubs. The goal is not to destroy the entire fleet but to inflict enough damage to force a retreat or weaken their defenses. Immediately disengage after the strike, using your ship’s speed or cloaking device to escape retaliation. Repeat this process across multiple locations, gradually eroding the Grox’s ability to respond effectively.
A critical aspect of this tactic is patience. The Grox’s defenses are formidable, and attempting to rush the process will likely result in your defeat. Instead, focus on consistency and precision. Each hit-and-run mission should be planned meticulously, taking into account the Grox’s patrol routes and reinforcement times. Over time, their fleets will become thinner, their outposts more vulnerable, and their ability to coordinate attacks diminished. This gradual weakening creates opportunities for larger-scale assaults later in the campaign.
One practical tip is to use decoys or distractions to draw Grox forces away from your primary target. For example, deploying a sacrificial drone or triggering a false alarm can create openings for your strike team. Additionally, upgrading your ship’s speed, weapons, and stealth capabilities will significantly enhance your effectiveness in these missions. Remember, the key is not to outmatch the Grox in open combat but to outmaneuver them through cunning and persistence.
In conclusion, guerilla tactics offer a viable path to dismantling the Grox empire in *Spore*. By leveraging hit-and-run strategies, players can systematically weaken their defenses without exposing themselves to overwhelming force. This method requires careful planning, patience, and a focus on long-term gains over short-term victories. With persistence, even the mightiest empires can be brought to their knees.
Mastering Fungal Spore Counting: Techniques and Tools for Accurate Results
You may want to see also

Economic Sabotage: Destroy Grox trade routes and resource hubs to cripple their economy
The Grox empire thrives on interstellar trade and resource exploitation. Their vast network of trade routes and resource hubs forms the backbone of their economy, fueling their military might and expansionist ambitions. To cripple the Grox, you must target this economic lifeline.
Identify and Disrupt Trade Routes:
Grox trade routes are often marked by frequent ship traffic and resource-rich systems. Use your empire’s spy network or reconnaissance ships to map these routes. Once identified, deploy fleets to intercept and destroy Grox cargo ships. Focus on high-traffic corridors and choke points where disruption will have maximum impact. For added efficiency, use stealth ships to avoid detection while sabotaging their supply lines.
Target Resource Hubs:
Grox resource hubs are typically located in systems with abundant minerals, spices, or energy sources. These hubs are critical for their industrial output and war efforts. Launch surgical strikes on mining facilities, refineries, and storage depots. Use planet-cracking weapons or biological agents to render resource-rich planets uninhabitable, forcing the Grox to divert resources to reclaim or replace them.
Economic Fallout and Strategic Timing:
Disrupting trade routes and resource hubs will create a ripple effect throughout the Grox economy. Reduced resource flow will slow their shipbuilding, weaken their military, and hinder their ability to maintain control over conquered territories. Time your sabotage to coincide with their military campaigns or internal unrest for maximum impact. A weakened economy will make them vulnerable to rebellion or external invasion.
Cautions and Countermeasures:
Economic sabotage is not without risk. The Grox will retaliate by increasing security along trade routes and fortifying resource hubs. Avoid direct confrontation with their fleets unless you have a numerical or technological advantage. Instead, rely on hit-and-run tactics and guerrilla warfare. Additionally, be prepared for the Grox to adapt by diversifying their trade routes or developing alternative resource sources. Stay one step ahead by continuously gathering intelligence and adjusting your strategy.
By systematically dismantling the Grox economy, you undermine their ability to sustain their empire. Economic sabotage is a long-term strategy that requires patience, precision, and persistence. However, with careful planning and execution, you can cripple the Grox from within, paving the way for their eventual downfall.
Do Mold Spores Grow Mushrooms? Unraveling the Fungal Connection
You may want to see also
Frequently asked questions
Yes, it is possible to destroy all the Grox, but it requires significant resources, advanced technology, and strategic planning.
The most effective method is to use a heavily upgraded spaceship with maxed-out weapons, armor, and shields, along with a large supply of repair kits and fuel.
Yes, you must destroy all Grox homeworlds and colonies, as they will repopulate if any remain. Use the "Planet Buster" tool to ensure complete eradication.
While allies can assist in battles, the Grox are too powerful for most empires to handle. It’s best to rely on your own advanced technology and resources.
Once the Grox are eliminated, their territory becomes available for colonization, and you’ll receive a special achievement. However, the game’s end goal remains the same.